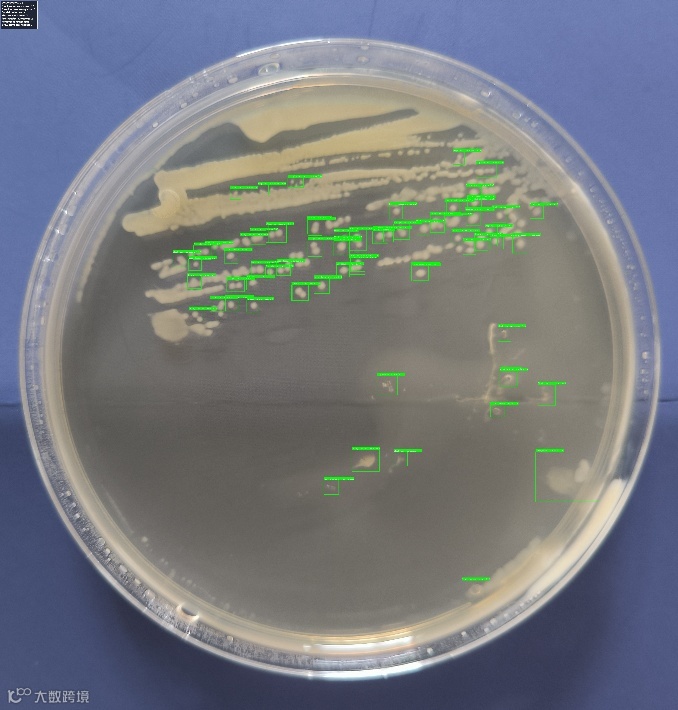

AI鉴别环境中分离出的菌(如细菌、真菌等)通常结合图像分析、基因序列比对、质谱数据处理等多种技术手段。
关键词:AI、菌落图像的识别、基因测序、16S rRNA。
01 基于菌落图像的识别(计算机视觉)
在培养皿中培养微生物后,通过高分辨率相机拍摄菌落图像。使用卷积神经网络(CNN)对菌落的形状、颜色、边缘、纹理、大小等特征进行分类。如Google 的 AI 研究团队曾开发用于识别尿液培养皿中致病菌的深度学习系统,准确率接近临床微生物学家水平。

02 基于基因测序数据的识别(生物信息学 + AI)
常用技术:16S rRNA(细菌)或 ITS(真菌)扩增子测序、宏基因组测序。将测序得到的DNA片段与参考数据库(如 SILVA、Greengenes、NCBI)比对。利用深度学习模型(如 LSTM、Transformer)直接从原始序列预测物种分类。

03 通过基质辅助激光解吸电离飞行时间质谱(MALDI-TOF MS)获取微生物的蛋白质指纹图谱。

使用机器学习(如 SVM、随机森林)或深度学习对质谱峰模式进行分类。模型训练依赖于已知菌株的质谱数据库。
结合图像、基因、质谱、生长曲线等多源数据,利用多模态深度学习模型提升识别准确率。


